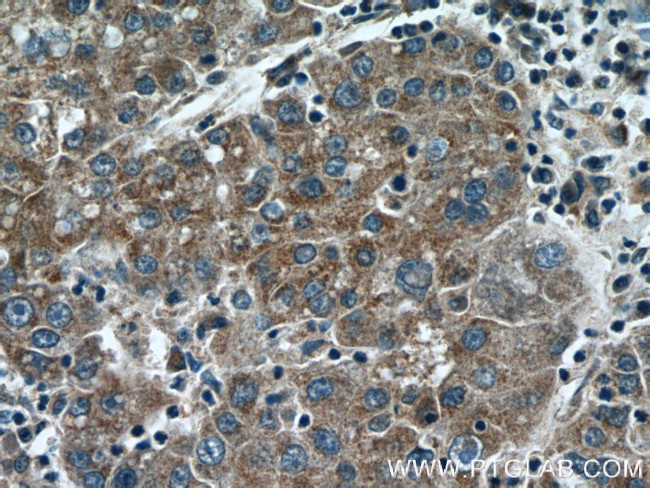
KLHL21 Antibody in Immunohistochemistry (Paraffin) (IHC (P))

Search
Proteintech
KLHL21 Polyclonal Antibody
{{$productOrderCtrl.translations['antibody.pdp.commerceCard.promotion.promotions']}}
{{$productOrderCtrl.translations['antibody.pdp.commerceCard.promotion.viewpromo']}}
{{$productOrderCtrl.translations['antibody.pdp.commerceCard.promotion.promocode']}}: {{promo.promoCode}} {{promo.promoTitle}} {{promo.promoDescription}}. {{$productOrderCtrl.translations['antibody.pdp.commerceCard.promotion.learnmore']}}
产品信息
16952-1-AP
种属反应
宿主/亚型
分类
类型
抗原
偶联物
形式
浓度
规格
纯化类型
保存液
内含物
保存条件
运输条件
产品详细信息
Immunogen sequence: AEPLVARCP PCLRLLREAR DFQAARYDRH DRGPCPRMRP RPSTGLAEIL VLVGGCDQDC DELVTVDCYN PQTGQWRYLA EFPDHLGGGY SIVALGNDIY VTGGSDGSRL YDCVWRYNSS VNEWAEVAPM LKAREYHSSS VLDGLLYVVA ADSTERYDHT TDSWEALQPM TYPMDNCSTT ACRGRLYAIG SLAGKETMVM QCYDPDTDLW SLVDCGQLPP WSFAPKTATL NGLMYFVRDD SAEVDVYNPT RNEWDKIPSM NQVHVGGSLA VLGGKLYVSG GYDNTFELSD VVEAYDPETR AWSVVGRLPE PTFWHGSVSI FRQFMPQTFS GGRGFELDSG SDDMDPGRPR PPRDPDELH (240-597 aa encoded by BC034039)
靶标信息
Substrate-specific adapter of a BCR (BTB-CUL3-RBX1) E3 ubiquitin-protein ligase complex required for efficient chromosome alignment and cytokinesis. The BCR(KLHL21) E3 ubiquitin ligase complex regulates localization of the chromosomal passenger complex (CPC) from chromosomes to the spindle midzone in anaphase and mediates the ubiquitination of AURKB. Ubiquitination of AURKB by BCR(KLHL21) E3 ubiquitin ligase complex may not lead to its degradation by the proteasome.
仅用于科研。不用于诊断过程。未经明确授权不得转售。
生物信息学
蛋白别名: kelch-like 21; Kelch-like protein 21; MGC99635; unnamed protein product
基因别名: 1810045K06Rik; D330008A20; KIAA0469; KLHL21; mKIAA0469; RGD1305863
UniProt ID: (Human) Q9UJP4, (Mouse) Q3U410, (Rat) D4A2K4
Entrez Gene ID: (Human) 9903, (Mouse) 242785, (Rat) 313743